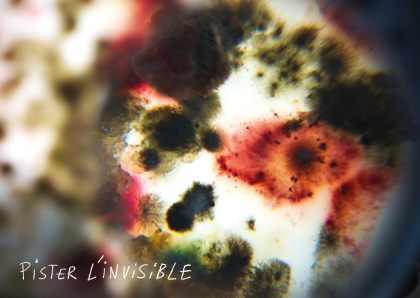
Pister l'invisible : résidence

- Culture
Visite curieuse | Pister l'invisible au Théâtre Francine Vasse
-
Le 12 mars 2026 de 18:00 à 21:00false false
-
18h > 21h
Après deux ans de résidence à Nantes Université, les artistes du Collectif de la Meute proposent une soirée de performances pour raconter joyeusement leur exploration des vivant·es invisibles qui nous entourent. Poussez les portes du Théâtre Francine Vasse pour découvrir ce lieu à taille humaine dédié à la création et aux pratiques artistiques, et assister à cette sortie de résidence !

Durant cette soirée, découvrez le récit d'une résidence d'artistes à Nantes Université qui s'est interrogée sur nos rapports aux vivant·es avec étudiant·es, enseignant·es chercheur·es et personnels comme complices : une performance mêlant paroles glanées dans les labos, expérimentations filmiques, danse et improvisations musicales pour microbiote.
Programme de la soirée
- 18h : Visite du Théâtre Francine Vasse
- 19h : Sortie de résidence Pister l'invisible du Collectif de la Meute. Plus d'infos.
- 20h : Temps convivial et d'échanges autour de la résidence d'artistes
Jauge : 20 places (Réservé aux étudiant·es de Nantes Université, quelques places disponibles pour les membres du personnel)
Dans le cadre de Pister l'invisible, une résidence d'artistes à Nantes Université imaginée par la Direction culture avec le Collectif de la Meute.
L'offre culturelle à Nantes Université
- Les ateliers de pratique
- Les Visites curieuses
- Le tarif Super Offert = 0€
- Résidences et créations partagées